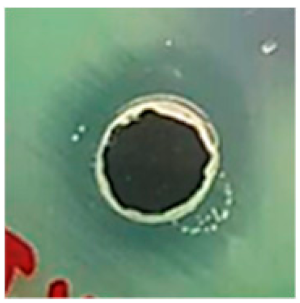
Biomolecules 09 00662 i002 Biomolecules 09 00662 i002
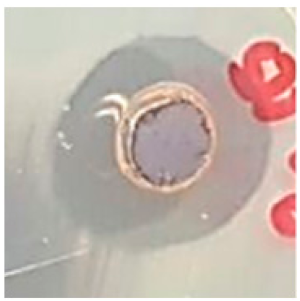
Biomolecules 09 00662 i016 Biomolecules 09 00662 i016

One-step Synthesis of Silver Nanoparticles Using Saudi Arabian Desert Seasonal Plant Sisymbrium irio and Antibacterial Activity Against Multidrug-Resistant Bacterial Strains
Abstract
1. Introduction
2. Materials and Methods
2.1. Chemicals
2.2. Collection of the Plant Material
2.3. Collection of Bacterial Pathogens
2.4. Identification of Bacterial Strains
2.5. Synthesis of Ag NPs
2.6. Characterization
2.7. Antibacterial Assay
2.8. Statistical Analysis
3. Results
3.1. UV-Vis Spectroscopic Analysis
3.2. FTIR Analysis of Synthesized Ag NPs
3.3. XRD Analysis
3.4. SEM, TEM, and Selected Area Electron Diffraction (SAED) Analysis of Ag NPs
3.5. Antibacterial Activity
4. Discussion
5. Conclusions
Author Contributions
Funding
Acknowledgments
Conflicts of Interest
References
- Al-Ansari, M.; Alkubaisi, N.; Gopinath, K.; Karthika, V.; Arumugam, A.; Govindarajan, M. Facile and Cost-Effective Ag Nanoparticles Fabricated by Lilium lancifolium Leaf Extract: Antibacterial and Antibiofilm Potential. J. Clust. Sci. 2019, 30, 1081–1089. [Google Scholar] [CrossRef]
- Huang, H.; Yang, X. Synthesis of polysaccharide-stabilized gold and silver nanoparticles: A green method. Carbohyd. Res. 2004, 339, 2627–2631. [Google Scholar] [CrossRef] [PubMed]
- Vinod, V.T.P.; Saravanan, P.; Sreedhar, B.; Devi, D.K.; Sashidhar, R.B. A facile synthesis and characterization of Ag, Au and Pt nanoparticles using a natural hydrocolloid gum kondagogu (Cochlospermum gossypium). Colloid. Surfaces B. 2011, 83, 291–298. [Google Scholar] [CrossRef] [PubMed]
- Kumar, K.M.; Mandal, B.K.; Kumar, K.S.; Reddy, P.S.; Sreedhar, B. Biobased green method to synthesise palladium and iron nanoparticles using Terminalia chebula aqueous extract. Spectrochim. Acta A. 2013, 102, 128–133. [Google Scholar] [CrossRef] [PubMed]
- Yuan, Z.; Li, R.; Meng, F.; Zhang, J.; Zuo, K.; Han, E. Approaches to Enhancing Gas Sensing Properties: A Review. Sensors 2019, 19, 1495. [Google Scholar] [CrossRef] [PubMed]
- Rajaei, E.; Ravandi, S.A.H.; Valipouri, A. Electrochemical and photovoltaic properties of dye-sensitized solar cells based on Ag-doped TiO2 nanorods. Optik 2018, 158, 514–521. [Google Scholar] [CrossRef]
- Rehan, M.; Mashaly, H.M.; Mowafi, S.; El-Kheir, A.A.; Emam, H.E. Multi-functional textile design using in-situ Ag NPs incorporation into natural fabric matrix. Dyes Pigments. 2015, 118, 9–17. [Google Scholar] [CrossRef]
- Zhang, Y.; Wang, L.; Kong, X.; Jiang, H.; Zhang, F.; Shi, J. Novel Ag-Cu bimetallic alloy decorated near-infrared responsive three-dimensional rod-like architectures for efficient photocatalytic water purification. J. Colloid Interf. Sci. 2018, 522, 29–39. [Google Scholar] [CrossRef]
- Sallum, L.F.; Soares, F.L.F.; Ardila, J.A.; Carneiro, R.L. Optimization of SERS scattering by Ag-NPs-coated filter paper for quantification of nicotinamide in a cosmetic formulation. Talanta 2014, 118, 353–358. [Google Scholar] [CrossRef]
- Sarwar, M.S.; Niazi, M.B.K.; Jahan, Z.; Ahmad, T.; Hussain, A. Preparation and characterization of PVA/nanocellulose/Ag nanocomposite films for antimicrobial food packaging. Carbohyd. Polym. 2018, 184, 453–464. [Google Scholar] [CrossRef]
- Anandan, M.; Poorani, G.; Boomi, P.; Varunkumar, K.; Anand, K.; Chuturgoon, A.A.; Saravanan, M.; Prabu, H.G. Green synthesis of anisotropic silver nanoparticles from the aqueous leaf extract of Dodonaea viscosa with their antibacterial and anticancer activities. Process Biochem. 2019, 80, 80–88. [Google Scholar] [CrossRef]
- Alharbi, N.S.; Govindarajan, M.; Kadaikunnan, S.; Khaled, J.M.; Almanaa, T.N.; Alyahya, S.A.; Al-Anbr, M.N.; Gopinath, K.; Sudha, A. Nanosilver crystals capped with Bauhinia acuminata phytochemicals as new antimicrobials and mosquito larvicides. J. Trace Elem. Med. Bio. 2018, 50, 146–153. [Google Scholar] [CrossRef] [PubMed]
- Bello, B.A.; Khan, S.A.; Khan, J.A.; Syed, F.Q.; Mirza, M.B.; Shah, L.; Khan, S.B. Anticancer, antibacterial and pollutant degradation potential of silver nanoparticles from Hyphaene thebaica. Biochem. Bioph. Res. Co. 2017, 490, 889–894. [Google Scholar] [CrossRef] [PubMed]
- Hebbalalu, D.; Lalley, J.M.; Nadagouda, N.; Varma, R.S. Greener Techniques for the Synthesis of Silver Nanoparticles Using Plant Extracts, Enzymes, Bacteria, Biodegradable Polymers, and Microwaves. ACS Sustain. Chem. Eng. 2013, 1, 703–712. [Google Scholar] [CrossRef]
- Kuppusamy, P.; Yusoff, M.M.; Maniam, G.P.; Govindan, N. Biosynthesis of metallic nanoparticles using plant derivatives and their new avenues in pharmacological applications—An updated report. Saudi Pharm. J. 2016, 24, 473–484. [Google Scholar] [CrossRef] [PubMed]
- Gopinath, K.; Kumaraguru, S.; Bhakyaraj, K.; Mohan, S.; Venkatesh, K.S.; Esakkirajan, M.; Kaleeswarran, P.; Alharbi, N.S. Green synthesis of silver, gold and silver/gold bimetallic nanoparticles using the Gloriosa superba leaf extract and their antibacterial and antibiofilm activities. Micro. Pathog. 2016, 101, 1–11. [Google Scholar] [CrossRef] [PubMed]
- Pirtarighat, S.; Ghannadnia, M.; Baghshahi, S. Green synthesis of silver nanoparticles using the plant extract of Salvia spinosa grown in vitro and their antibacterial activity assessment. J. Nanostruct. Chem. 2019, 9, 1–9. [Google Scholar] [CrossRef]
- Prabakar, K.; Sivalingam, P.; Rabeek, S.I.M.; Muthuselvam, M.; Devarajan, N.; Arjunan, A.; Karthick, R.M.; Suresh, M.; Wembonyama, J.P. Evaluation of antibacterial efficacy of phyto fabricated silver nanoparticles using Mukia scabrella (Musumusukkai) against drug resistance nosocomial gram negative bacterial pathogens. Colloid. Surface B. 2013, 104, 282–288. [Google Scholar] [CrossRef]
- Yugandhar, P.; Savithramma, N. Biosynthesis, characterization and antimicrobial studies of green synthesized silver nanoparticles from fruit extract of Syzygium alternifolium (Wt.) Walp. an endemic, endangered medicinal tree taxon. Appl. Nanosci. 2016, 6, 223–233. [Google Scholar] [CrossRef]
- Al-Jaber, N.A. Phytochemical and biological studies of Sisymbrium irio L. Growing in Saudi Arabia. J. Saudi Chem. Soc. 2011, 15, 345–350. [Google Scholar] [CrossRef]
- Al-Massarani, S.M.; El-Gamal, A.A.; Alam, P.; Al-Sheddi, E.S.; Al-Oqail, M.M.; Farshori, N.N. Isolation, biological evaluation and validated HPTLC-quantification of the marker constituent of the edible Saudi plant Sisymbrium irio L. S. Pharm. J. 2017, 25, 750–759. [Google Scholar] [CrossRef] [PubMed]
- Jeyaseelan, S.; Revathi, P.; Rath, P.K.; Suresh, M.; Vigeneshwari, R.S.; Uma, A.; Subramanian, P.T.K.; Moorthy, K.; Thajuddin, N. Antimicrobial Resistant Pattern of Gram Negative Bacteria to Third Generation Cephalosporins in Rural and Urban Centres of Tamil nadu, India. Int. J. Bioliogical. Tech. 2012, 3, 32–38. [Google Scholar]
- Kannaiyan, M.; Manuel, V.N.; Raja, V.; Thambidurai, P.; Mickymaray, S.; Nooruddin, T. Antimicrobial activity of the ethanolic and aqueous extracts of Salacia chinensis Linn. against human pathogens. Asian Pac. J. Trop. Dis. 2012, 2, 416–420. [Google Scholar] [CrossRef]
- Mickymaray, S.; Alturaiki, W.; Al-Aboody, M.S.; Mariappan, P.; Rajenderan, V.; Alsagaby, S.A.; Kalyanasundram, U.; Alarfajj, A.A. Anti-bacterial efficacy of bacteriocin produced by marine Bacillus subtilis against clinically important extended spectrum beta-lactamase strains and methicillin-resistant Staphylococcus aureus. Int. J. Med. Res. Health Sci. 2018, 7, 75–83. [Google Scholar]
- Mickymaray, S.; Alturaiki, W. Antifungal efficacy of marine macroalgae against fungal isolates from bronchial asthmatic cases. Molecules 2018, 23, 3032. [Google Scholar] [CrossRef]
- Mickymaray, S.; Al Aboody, M.S. In Vitro Antioxidant and Bactericidal Efficacy of 15 Common Spices: Novel Therapeutics for Urinary Tract Infections? Medicina 2019, 55, 289. [Google Scholar] [CrossRef]
- Saranya, A.S.; Suresh, M.; Al Aboody, M.S.; Rath, P.K.; Kibemo, B.; Kannaiyan, M. Prevalence of metallo β-lactamases in carbapenem resistant Acinetobacter Baumannii isolated from tracheal secretions. Int. J. Recent Sci. Res. 2017, 8, 15197–15202. [Google Scholar]
- Falagas, M.E.; Tansarli, G.S.; Karageorgopoulos, D.E.; Vardakas, K.Z. Deaths Attributable to Carbapenem-Resistant Enterobacteriaceae Infections. Emerg. Infect. Dis. 2014, 20, 1170. [Google Scholar] [CrossRef]
- Lemos, E.V.; de La Hoz, F.P.; Einarson, T.R.; McGhan, W.F.; Quevedo, E.; Castaneda, C.; Kawai, K. Carbapenem resistance and mortality in patients with Acinetobacter baumannii infection: Systematic review and meta-analysis. Clin. Microbiol. Infec. 2014, 20, 416–423. [Google Scholar] [CrossRef]
- Shamsizadeh, Z.; Nikaeen, M.; Esfahani, B.N.; Mirhoseini, S.H.; Hatamzadeh, M.; Hassanzadeh, A. Detection of antibiotic resistant Acinetobacter baumannii in various hospital environments: Potential sources for transmission of Acinetobacter infections. Environ. Health Prev. 2017, 22, 44. [Google Scholar] [CrossRef]
- Fournier, P.E.; Richet, H.; Weinstein, R.A. The Epidemiology and Control of Acinetobacter baumannii in Health Care Facilities. Clin. Infect. Dis. 2006, 42, 692–699. [Google Scholar] [CrossRef] [PubMed]
- Kilic, A.; Li, H.; Mellmann, A.; Basustaoglu, A.C.; Kul, A.C.; Senses, Z.; Aydogan, H.; Stratton, C.W.; Harmsen, D.; Tang, Y.W. Acinetobacter septicus sp. nov. Association with a Nosocomial Outbreak of Bacteremia in a Neonatal Intensive Care Unit. J. Clin. Microbio. 2008, 46, 902–908. [Google Scholar] [CrossRef] [PubMed]
- Mickymaray, S.; Al Aboody, M.S.; Rath, P.K.; Annamalai, P.; Nooruddin, T. Screening and antibacterial efficacy of selected Indian medicinal plants. Asian Pac. J. Trop. Biomed. 2016, 6, 185–191. [Google Scholar] [CrossRef]
- Lim, S.S.; Selvaraj, A.; Ng, Z.Y.; Palanisamy, M.; Mickymaray, S.; Cheong, P.C.H.; Lim, R.L.H. Isolation of actinomycetes with antibacterial activity against multi-drug resistant bacteria. Malays. J. Microbiol. 2018, 14, 293–305. [Google Scholar]
- Gopinath, K.; Gowri, S.; Arumugam, A. Phytosynthesis of silver nanoparticles using Pterocarpus santalinus leaf extract and their antibacterial properties. J. Nanostruct. Chem. 2013, 3, 68. [Google Scholar] [CrossRef]
- Krishnaraj, C.; Ramachandran, R.; Mohan, K.; Kalaichelvan, P.T. Optimization for rapid synthesis of silver nanoparticles and its effect on phytopathogenic fungi. Spectrochim. Acta A. 2012, 93, 95–99. [Google Scholar] [CrossRef] [PubMed]
- Perez, C. Antibiotic assay by agar-well diffusion method. Acta Biol. Med. Exp. 1990, 15, 113–115. [Google Scholar]
- Jayaseelan, C.; Rahuman, A.A.; Rajakumar, G.; Kirthi, A.V.; Santhoshkumar, T.; Marimuthu, S.; Bagavan, A.; Kamaraj, C.; Zahir, A.A.; Elango, G. Synthesis of pediculocidal and larvicidal silver nanoparticles by leaf extract from heartleaf moonseed plant, Tinospora cordifolia Miers. Parasitol. Res. 2011, 109, 185–194. [Google Scholar] [CrossRef]
- Anuj, S.A.; Ishnava, K.B. Plant mediated synthesis of silver nanoparticles by using dried stem powder of Tinospora cordifolia, its antibacterial activity and comparison with antibiotics. Int. J. Pharma. Biol. Sci. 2013, 4, 849–863. [Google Scholar]
- Singh, K.; Panghal, M.; Kadyan, S.; Chaudhary, U.; Yadav, J.P. Antibacterial Activity of Synthesized Silver Nanoparticles from Tinospora cordifolia against Multi Drug Resistant Strains of Pseudomonas aeruginosa Isolated from Burn Patients. J. Nanomed. Nanotechnol. 2014, 5, 192. [Google Scholar] [CrossRef]
- López-Miranda, J.L.; Vázquez, M.; Fletes, N.; Esparza, R.; Rosas, G. Biosynthesis of silver nanoparticles using a Tamarix gallica leaf extract and their antibacterial activity. Mater. Lett. 2016, 176, 285–289. [Google Scholar] [CrossRef]
- Ravichandran, V.; Vasanthi, S.; Shalini, S.; Shah, S.A.A.; Harish, R. Green synthesis of silver nanoparticles using Atrocarpus altilis leaf extract and the study of their antimicrobial and antioxidant activity. Mater. Lett. 2016, 180, 264–267. [Google Scholar] [CrossRef]
- Krishnaraj, C.; Jagan, E.G.; Rajasekar, S.; Selvakumar, P.; Kalaichelvan, P.T.; Mohan, N. Synthesis of silver nanoparticles using Acalypha indica leaf extracts and its antibacterial activity against water borne pathogens. Colloid. Surface. B. 2010, 76, 50–56. [Google Scholar] [CrossRef] [PubMed]
- Rajeshkumar, S.; Kannan, C.; Annadurai, G. Synthesis and Characterization of Antimicrobial Silver Nanoparticles Using Marine Brown Seaweed Padina tetrastromatica. Drug Invent. Today. 2012, 4, 511–513. [Google Scholar]
- Durán, N.; Marcato, P.D.; De Souza, G.I.; Alves, O.L.; Esposito, E. Antibacterial Effect of Silver Nanoparticles Produced by Fungal Process on Textile Fabrics and Their Effluent Treatment. J. Biomed. Nanotechnol. 2007, 3, 203–208. [Google Scholar] [CrossRef]
- Umashankari, J.; Inbakandan, D.; Ajithkumar, T.T.; Balasubramanian, T. Mangrove plant, Rhizophora mucronata (Lamk, 1804) mediated one pot green synthesis of silver nanoparticles and its antibacterial activity against aquatic pathogens. Aquat. Biosyst. 2012, 8, 11. [Google Scholar] [CrossRef]
- Vanaja, M.; Annadurai, G. Coleus aromaticus leaf extract mediated synthesis of silver nanoparticles and its bactericidal activity. Appl. Nanosci. 2013, 3, 217–223. [Google Scholar] [CrossRef]
- Chowdhury, S.; Basu, A.; Kundu, S. Green synthesis of protein capped silver nanoparticles from phytopathogenic fungus Macrophomina phaseolina (Tassi) Goid with antimicrobial properties against multidrug-resistant bacteria. Nanoscale Res. Lett. 2014, 9, 365. [Google Scholar] [CrossRef]
- Anandalakshmi, K.; Venugobal, J.; Ramasamy, V. Characterization of silver nanoparticles by green synthesis method using Pedalium murex leaf extract and their antibacterial activity. Appl. Nanosci. 2016, 6, 399–408. [Google Scholar] [CrossRef]
- Jyoti, K.; Baunthiyal, M.; Singh, A. Characterization of silver nanoparticles synthesized using Urtica dioica Linn. leaves and their synergistic effects with antibiotics. J. Radiat. Res. Appl. Sci. 2016, 9, 217–227. [Google Scholar] [CrossRef]
- Behravan, M.; Panahi, A.H.; Naghizadeh, A.; Ziaee, M.; Mahdavi, R.; Mirzapour, A. Facile green synthesis of silver nanoparticles using Berberis vulgaris leaf and root aqueous extract and its antibacterial activity. Int. J. Bio. Macromol. 2019, 124, 148–154. [Google Scholar] [CrossRef] [PubMed]
- Mittal, A.K.; Chisti, Y.; Banerjee, U.C. Synthesis of metallic nanoparticles using plant extracts. Biotechnol. Adv. 2013, 31, 346–356. [Google Scholar] [CrossRef] [PubMed]
- Xu, Z.; He, L.; Mu, R.; Zhong, X.; Cao, X. Formation of diffusion barrier on the Ni-based superalloy by low-pressure pre-oxidation. Vacuum 2008, 82, 1251–1258. [Google Scholar] [CrossRef]
- WHO Publishes List of Bacteria for Which New Antibiotics are Urgently Needed. Geneva. Available online: http://www.who.int/mediacentre/news/releases/2017/bacteria-antibiotics-needed/en/ (accessed on 26 September 2019).
- Nys, S.; Terporten, P.H.; Korstanje, J.A.A.H.; Stobberingh, E.E. Trends in antimicrobial susceptibility of Escherichia coli isolates from urology services in the Netherlands (1998–2005). J. Antimicrob Chemother 2008, 62, 126–132. [Google Scholar] [CrossRef]
- Vijayakumar, R.; Sandle, T.; Al-Aboody, M.S.; AlFonaisan, M.K.; Alturaiki, W.; Mickymaray, S.; Premanathan, M.; Alsagaby, S.A. Distribution of biocide resistant genes and biocides susceptibility in multidrug-resistant Klebsiella pneumoniae, Pseudomonas aeruginosa and Acinetobacter baumannii—A first report from the Kingdom of Saudi Arabia. J. Infect. Public Health. 2018, 11, 812–816. [Google Scholar] [CrossRef]
- Chen, M.; Yu, X.; Huo, Q.; Yuan, Q.; Li, X.; Xu, C.; Bao, H. Biomedical Potentialities of Silver Nanoparticles for Clinical Multiple Drug-Resistant Acinetobacter baumannii. J. Nanomater. 2019, 2019, 7. [Google Scholar] [CrossRef]
- Jinu, U.; Jayalakshmi, N.; Anbu, A.S.; Mahendran, D.; Sahi, S.; Venkatachalam, P. Biofabrication of Cubic Phase Silver Nanoparticles Loaded with Phytochemicals from Solanum nigrum Leaf Extracts for Potential Antibacterial, Antibiofilm and Antioxidant Activities Against MDR Human Pathogens. J. Clust. Sci. 2017, 28, 489–505. [Google Scholar] [CrossRef]
- Kasithevar, M.; Periakaruppan, P.; Muthupandian, S.; Mohan, M. Antibacterial efficacy of silver nanoparticles against multi-drug resistant clinical isolates from post-surgical wound infections. Micro. Pathog. 2017, 107, 327–334. [Google Scholar] [CrossRef]







| Antibiotics Group | Concentration (µg) | P. aeruginosa | A. baumannii | E. coli (ATCC: 25922) |
|---|---|---|---|---|
| Aminoglycosides | ||||
| Amikacin (AN) | 8; 16; 64 | R* | R | S** |
| Gentamicin (GM) | 4; 16; 32 | R | R | S |
| Tobramycin (TM) | 8; 16; 64 | R | R | S |
| Carbapenems | ||||
| Ertapenem (ETP) | 0.1; 6 | S | S | S |
| Imipenem (IPM) | 1; 2; 6; 12 | S | S | S |
| Meropenem (MEM) | 0.5,2,6,12 | S | S | S |
| Cephalosporins | ||||
| Ceftazidime (CAZ) | 1; 2; 8; 32 | R | R | S |
| Cefepime (FEP) | 2; 8; 26; 32 | R | R | S |
| Fluoroquinolones | ||||
| Ciprofloxacin (CIP) | 0.5; 2; 4 | R | R | S |
| Levofloxacin (LEV) | 0.25; 0.5; 2; 8 | R | R | S |
| Tetracyclines Tigecycline | 0.75; 2; 4 | R | R | S |
| Polypeptides Colistin (CS) | 4; 16; 32 | S | S | S |
| Co-Trimoxzalole Trimethoprim/Sulphonamides | 1/19; 4/76; 16/304 | R | R | S |
| Organism | Concentration of Ag NPS | Meropenem | ||||
|---|---|---|---|---|---|---|
| 6.25 µg | 12.5 µg | 25 µg | 50 µg | 100 µg | (10 µg) | |
| Antibacterial Effect Against VAP Causing MDR Pathogens and Reference Strains | ||||||
| P. aeruginosa |  | |  |  |  |  |
| A. baumannii |  |  |  |  |  |  |
| E. coli (ATCC-25922) |  |  |  | |  |  |
© 2019 by the author. Licensee MDPI, Basel, Switzerland. This article is an open access article distributed under the terms and conditions of the Creative Commons Attribution (CC BY) license (http://creativecommons.org/licenses/by/4.0/).
Share and Cite
Mickymaray, S. One-step Synthesis of Silver Nanoparticles Using Saudi Arabian Desert Seasonal Plant Sisymbrium irio and Antibacterial Activity Against Multidrug-Resistant Bacterial Strains. Biomolecules 2019, 9, 662. https://doi.org/10.3390/biom9110662
Mickymaray S. One-step Synthesis of Silver Nanoparticles Using Saudi Arabian Desert Seasonal Plant Sisymbrium irio and Antibacterial Activity Against Multidrug-Resistant Bacterial Strains. Biomolecules. 2019; 9(11):662. https://doi.org/10.3390/biom9110662
Chicago/Turabian StyleMickymaray, Suresh. 2019. "One-step Synthesis of Silver Nanoparticles Using Saudi Arabian Desert Seasonal Plant Sisymbrium irio and Antibacterial Activity Against Multidrug-Resistant Bacterial Strains" Biomolecules 9, no. 11: 662. https://doi.org/10.3390/biom9110662
APA StyleMickymaray, S. (2019). One-step Synthesis of Silver Nanoparticles Using Saudi Arabian Desert Seasonal Plant Sisymbrium irio and Antibacterial Activity Against Multidrug-Resistant Bacterial Strains. Biomolecules, 9(11), 662. https://doi.org/10.3390/biom9110662





